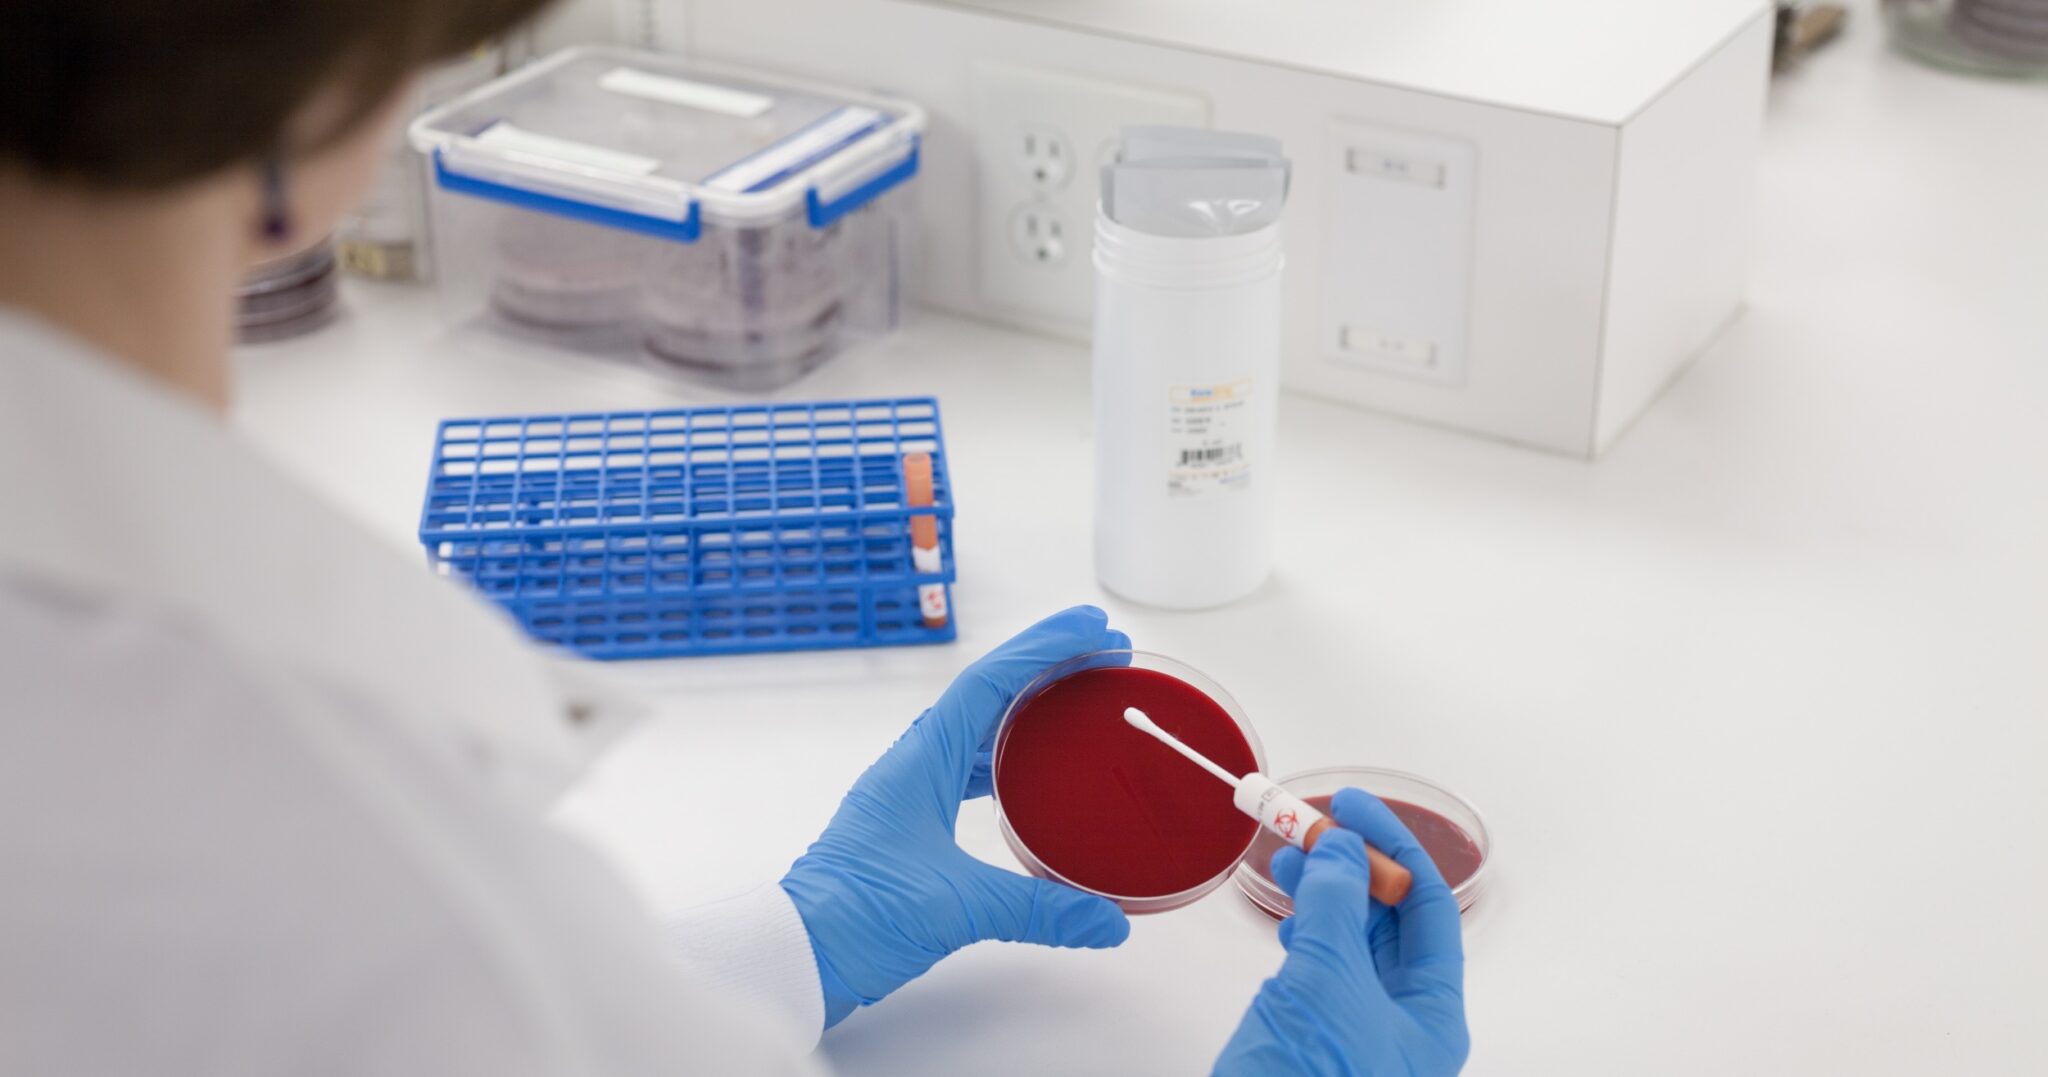

Microbiologics Catalog
Microbiologics Catalog - When replacing a component like a servo drive, it is critical to first back up all parameters from the old drive using the control interface, if possible. Thank you for choosing Ford. This practice can also promote a sense of calm and groundedness, making it easier to navigate life’s challenges. It is a comprehensive, living library of all the reusable components that make up a digital product. I no longer see it as a symbol of corporate oppression or a killer of creativity. Your Toyota Ascentia is equipped with a tilting and telescoping steering column, which you can adjust by releasing the lock lever located beneath it. 17 The physical effort and focused attention required for handwriting act as a powerful signal to the brain, flagging the information as significant and worthy of retention. I discovered the work of Florence Nightingale, the famous nurse, who I had no idea was also a brilliant statistician and a data visualization pioneer. The basic technique of crochet involves creating loops and stitches with a single hook. Conversely, someone from a family where vigorous debate was the norm may follow a template that seeks out intellectual sparring in their personal and professional relationships. Furthermore, drawing has therapeutic benefits, offering individuals a means of relaxation, stress relief, and self-expression. In the academic sphere, the printable chart is an essential instrument for students seeking to manage their time effectively and achieve academic success. You will need to remove these using a socket wrench. Finding ways to overcome these blocks can help you maintain your creativity and continue producing work. The most common of these is the document template, a feature built into every word processing application. 102 In this hybrid model, the digital system can be thought of as the comprehensive "bank" where all information is stored, while the printable chart acts as the curated "wallet" containing only what is essential for the focus of the current day or week. Focusing on positive aspects of life, even during difficult times, can shift one’s perspective and foster a greater sense of contentment. This entire process is a crucial part of what cognitive scientists call "encoding," the mechanism by which the brain analyzes incoming information and decides what is important enough to be stored in long-term memory. The key to a successful printable is high quality and good design. " While we might think that more choice is always better, research shows that an overabundance of options can lead to decision paralysis, anxiety, and, even when a choice is made, a lower level of satisfaction because of the nagging fear that a better option might have been missed. I embrace them. This type of chart empowers you to take ownership of your health, shifting from a reactive approach to a proactive one. It is a process that transforms passive acceptance into active understanding. When a single, global style of furniture or fashion becomes dominant, countless local variations, developed over centuries, can be lost. It’s a pact against chaos. The first principle of effective chart design is to have a clear and specific purpose. This is the semiotics of the material world, a constant stream of non-verbal cues that we interpret, mostly subconsciously, every moment of our lives. The ability to choose the exact size and frame is a major advantage. This is a monumental task of both artificial intelligence and user experience design. Pressing this button will connect you with an operator who can dispatch emergency services to your location. The principles of good interactive design—clarity, feedback, and intuitive controls—are just as important as the principles of good visual encoding. Whether we are looking at a simple document template, a complex engineering template, or even a conceptual storytelling template, the underlying principle remains the same. But it also empowers us by suggesting that once these invisible blueprints are made visible, we gain the agency to interact with them consciously. These are the subjects of our inquiry—the candidates, the products, the strategies, the theories. The myth of the lone genius who disappears for a month and emerges with a perfect, fully-formed masterpiece is just that—a myth. 3D printing technology has even been used to create custom crochet hooks and accessories, blending the traditional with the cutting-edge. This is a monumental task of both artificial intelligence and user experience design. It was a tool, I thought, for people who weren't "real" designers, a crutch for the uninspired, a way to produce something that looked vaguely professional without possessing any actual skill or vision. Canva has made graphic design accessible to many more people. A truncated axis, one that does not start at zero, can dramatically exaggerate differences in a bar chart, while a manipulated logarithmic scale can either flatten or amplify trends in a line chart. A printable chart, therefore, becomes more than just a reference document; it becomes a personalized artifact, a tangible record of your own thoughts and commitments, strengthening your connection to your goals in a way that the ephemeral, uniform characters on a screen cannot. I had to determine its minimum size, the smallest it could be reproduced in print or on screen before it became an illegible smudge. We now have tools that can automatically analyze a dataset and suggest appropriate chart types, or even generate visualizations based on a natural language query like "show me the sales trend for our top three products in the last quarter. Even something as simple as a urine color chart can serve as a quick, visual guide for assessing hydration levels. Schools and community programs are introducing crochet to young people, ensuring that the craft continues to thrive in the hands of future generations. Use a mild car wash soap and a soft sponge or cloth, and wash the vehicle in a shaded area. The way we communicate in a relationship, our attitude toward authority, our intrinsic definition of success—these are rarely conscious choices made in a vacuum. The feedback loop between user and system can be instantaneous. The culinary arts provide the most relatable and vivid example of this. There were four of us, all eager and full of ideas. While your conscious mind is occupied with something else, your subconscious is still working on the problem in the background, churning through all the information you've gathered, making those strange, lateral connections that the logical, conscious mind is too rigid to see. Many common issues can be resolved without requiring extensive internal repairs. This chart is typically a simple, rectangular strip divided into a series of discrete steps, progressing from pure white on one end to solid black on the other, with a spectrum of grays filling the space between. The product can then be sold infinitely without new manufacturing. There’s a wonderful book by Austin Kleon called "Steal Like an Artist," which argues that no idea is truly original. It's not just about waiting for the muse to strike. This experience taught me to see constraints not as limitations but as a gift. In his 1786 work, "The Commercial and Political Atlas," he single-handedly invented or popularised three of the four horsemen of the modern chart apocalypse: the line chart, the bar chart, and later, the pie chart. They are the first clues, the starting points that narrow the infinite universe of possibilities down to a manageable and fertile creative territory. The electronic parking brake is activated by a switch on the center console. This world of creative printables highlights a deep-seated desire for curated, personalized physical goods in an age of mass-produced digital content. It is a set of benevolent constraints, a scaffold that provides support during the messy process of creation and then recedes into the background, allowing the final, unique product to stand on its own. They don't just present a chart; they build a narrative around it. This sample is a radically different kind of artifact. 21 The primary strategic value of this chart lies in its ability to make complex workflows transparent and analyzable, revealing bottlenecks, redundancies, and non-value-added steps that are often obscured in text-based descriptions. It includes a library of reusable, pre-built UI components. This is the template evolving from a simple layout guide into an intelligent and dynamic system for content presentation. One of the most frustrating but necessary parts of the idea generation process is learning to trust in the power of incubation. An effective chart is one that is designed to work with your brain's natural tendencies, making information as easy as possible to interpret and act upon. The height of the seat should be set to provide a clear view of the road and the instrument panel. Using a PH000 screwdriver, remove these screws and the bracket. Lupi argues that data is not objective; it is always collected by someone, with a certain purpose, and it always has a context. As individuals gain confidence using a chart for simple organizational tasks, they often discover that the same principles can be applied to more complex and introspective goals, making the printable chart a scalable tool for self-mastery. The chart is essentially a pre-processor for our brain, organizing information in a way that our visual system can digest efficiently. They are easily opened and printed by almost everyone. Just as the artist charts shades of light to give form to a portrait, an individual can chart their principles to give form and direction to their life. The persistence and popularity of the printable in a world increasingly dominated by screens raises a fascinating question: why do we continue to print? In many cases, a digital alternative is more efficient and environmentally friendly. Combine unrelated objects or create impossible scenes to explore surrealism.KWIKSTIK Plus Fraser Indonesia
MICROBIOLOGICS Cepas de referencia ATCC MICROBIOLOGIA
QC Sets and Panels Helix Elite, Microbiologics Controls and
Enterococcus faecalis ATCC 29212 , Microbiologics 2/Pk. Buy Online
Microbial Testing TECHNOPATH
Microbiologics AB Scientific
Microbiologics Listeria monocytogenes ATCC 19112 KWIKSTIK; 2/Pk.Life
Microbiologics KwikStik 0354p 2 Pack Quality Control Organism 2
Microbiologics KwikStik 01189p 2 Pack Quality Control Organism 2
EZAccu Shot™ Select, Microbiologics Controls and Calibration
Microbiologics Epower Bacillus subtilis subsp. spizizenii, ATCC 6633
Microbiologics Intestinal Protozoa Control Slide Medline
Microbiologics Bacterial Vaginosis Control Panel Medline
microbiologics Plastlabor
Souches ATCC Microbiologie
Microbiologics SARSCoV2 Process Controls Medline
Microbiology Product Catalog EU en PDF Elisa Antibiotics
Microbiologics Enterococcus casseliflavus ATCC 700327 LYFO DISK; 6/Pk
Microbiologics Retail Catalog 40th Edition Web Version
KWIK STIK Fraser Indonesia
Catalogo Microbiologics ¿qué es microbiologics? CERTIFICACIONES
Microbiologics 8242 Rapid Group B Streptococcus (GBS) Control Panel QC
Microbiologics Molecular Controls Catalog PDF Serotype Influenza
Microbiologics expands product line
Microbiologics KwikStik 0312p 2 Pack Quality Control Organism 2
Microbiologics KwikStik 0982k 6 Pack Quality Control Organism 6
Microbiologics 8172 EZ Accu Shot™ Select
EZACCU SHOT SELECT Fraser Indonesia
Microbiologics MicroScan Dry Positive/Substrate and MIC QC Set 2/Pk
How to Maintain Monthly Working Stock Cultures with Microbiologics QC
Microbiologics Micrococcus luteus ATCC 10240 6 Pellets Buy Online
MİKROMED MEDİKAL
Microbiologics KwikStik 0990k 6 Pack Quality Control Organism 6
Related Post:

.jpg-650.jpg)







.jpg-650.jpg)














